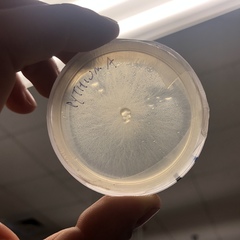
Pythium
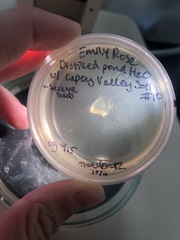
Pythium

Pythium: taxon details and analytics
- Domain
- Kingdom
- Chromista
- Phylum
- Oomycota
- Class
- Peronosporomycetes
- Order
- Peronosporales
- Family
- Pythiaceae
- Genus
- Pythium
- Species
- Scientific Name
- Pythium
Summary description from Wikipedia:
Pythium
Pythium is a genus of parasitic oomycetes. They were formerly classified as fungi. Most species are plant parasites, but Pythium insidiosum is an important pathogen of animals, causing pythiosis. The feet of the fungus gnat are frequently a vector for their transmission.
...Pythium in languages:
- Afrikaans
- Knolvrot
- Afrikaans
- Kroonvrot
- Afrikaans
- Saailingvrot
- Afrikaans
- Omvalsiektes
- Czech
- pytium
- Lithuanian
- Diegavertis
Images from inaturalist.org observations:
We recommend you sign up for this excellent, free service.